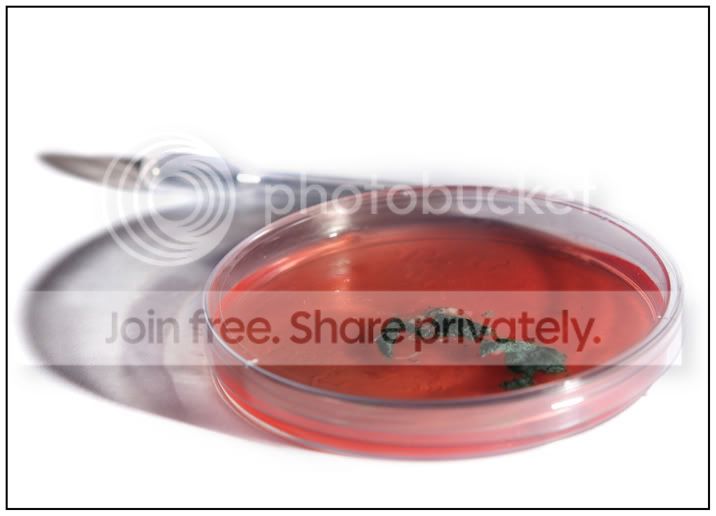
46-living2web.jpg
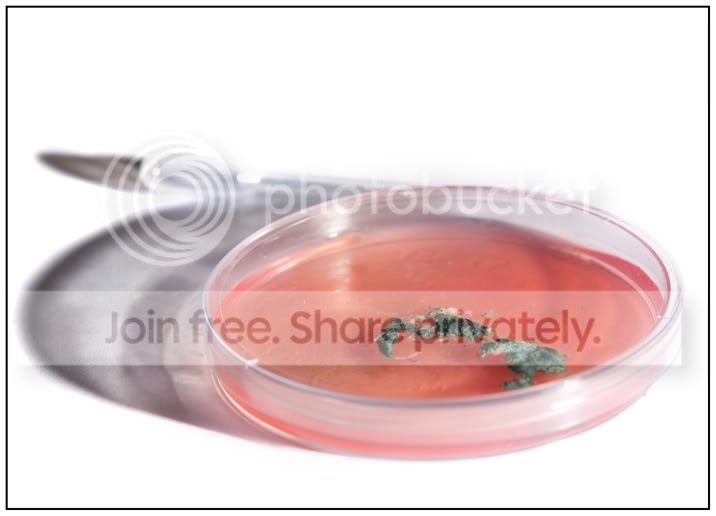
46-livingweb.jpg

captures.in.time
Suspended / Banned
- Messages
- 1,764
- Edit My Images
- Yes
Adie... The photo of the dictionary... mmm its not abstract to me... Yes you have a technically fab photo as always but I think this is the sort of photo that should be resisted when doing a 52! Just taking the word out the dictionary... I get it but I hate it! Sorry to sound so negative... I think you could pull something out the bag with this one thats a piece of your own art straight out the camera... I know you can!